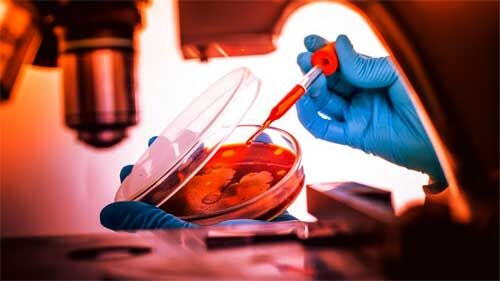
खुलासा : 5 साल से चीन-पाकिस्तान मिलकर बना रहे हैं जैविक हथियार, भारत के खिलाफ होगा उपयोग !

खुलासा : 5 साल से चीन-पाकिस्तान मिलकर बना रहे हैं जैविक हथियार, भारत के खिलाफ होगा उपयोग !
चीनी लैब के वैज्ञानिक पाकिस्तान के वैज्ञानिकों को दे रहे हैं ट्रेनिंग
नई दिल्ली। चीन की वुहान लैब पाकिस्तान के साथ मिलकर पिछले पांच सालों से खतरनाक जैविक हथियारों पर प्रयोग कर रही है। इसमें चीन का साथ दे रहा है उसका सदाबहार दोस्त पाकिस्तान। इस बात का खुलासा एक ऑस्ट्रेलियाई वेबसाइट 'द क्लाक्सोन' ने किया है। बताया जा रहा है कि यह रिसर्च 5 साल से चल रही है। क्या यह सब भारत के खिलाफ उपयोग होगा ?
क्या है इस रिपोर्ट में
इस रिपोर्ट में लिखा है कि चीन और पाकिस्तान ने पिछले ही महीने दुनिया से छुप कर आपस में तीन साल की एक डील की है। जिसके तहत चीन की वुहान इंस्टीट्यूट ऑफ वायरोलॉजी में जैविक हथियारों को बनाने का समझौता भी दोनों देशों के बीच हुआ है।
इतना ही नहीं, इस खबर का सबसे बड़ा खुलासा ये है कि चीन की वुहान लैब पाकिस्तान के साथ मिलकर साल 2015 से ही खतरनाक बैक्टीरिया-वायरस पर प्रयोग कर रही है।
>>यह रिसर्च दिसंबर 2017 से लेकर इस साल मार्च तक की गई। इसमें 'जूनोटिक पैथोजंस (जानवरों से इंसानों में आने वाले वायरस)' की पहचान और लक्षणों के बारे में बताया गया है।
>>एक रिसर्च में पाकिस्तान ने वुहान इंस्टीट्यूट को वायरस संक्रमित सेल्स मुहैया कराने के लिए शुक्रिया भी कहा था। इसके साथ ही रिसर्च को CPEC के तहत मिले सहयोग का भी जिक्र किया गया है।
>>रिसर्च में वेस्ट नील वायरस, मर्स-कोरोनावायरस, क्रीमिया-कॉन्गो हेमोरजिक फीवर वायरस, थ्रोम्बोसाइटोपेनिया सिंड्रोम वायरस और चिकनगुनिया पर भी प्रयोग किए गए हैं।
>>रिपोर्ट के मुताबिक रिसर्च के लिए हजारों पाकिस्तानी पुरुषों, महिलाओं और बच्चों का ब्लड सैम्पल लिया गया। इनमें वे लोग शामिल थे जो जानवरों के साथ काम करते थे और दूरदराज के इलाकों में रहते थे।
वुहान लैब और पाकिस्तान के वैज्ञानिकों ने अब तक पांच स्टडीज की हैं, जिसे साइंटिफिक पेपर्स में भी प्रकाशित कराया गया है। सभी शोध में पशुजन्यरोग की खोज और लक्षण के बारे में चर्चा की गई है, जिसकी वजह से संक्रामक बीमारियां जानवरों से इंसानों में फैलती हैं। पशुजन्यरोग के उदाहरण के तौर पर कोरोना वायरस का उल्लेख किया गया है। द क्लाक्सोन ने अपनी रिपोर्ट में लिखा है कि इन पांचों स्टडीज में कई घातक और संक्रामक बीमारियों के जीनोम सिक्वेंसिंग के बारे में भी लिखा है। बीमारियों के तौर पर वेस्ट नाइल वायरस, मर्स कोरोना वायरस, क्रिमियन-कॉन्गो हेमोरेजिक फीवर वायरस, द थ्रोम्बोसाइटोपेनिया सिंड्रोम वायरस और चिकनगुनिया वायरस का उल्लेख किया गया है।
रिपोर्ट के मुताबिक रिसर्च के लिए हजारों पाकिस्तानी पुरुषों, महिलाओं और बच्चों का ब्लड सैम्पल लिया गया। इसमें दूरदराज के रहने वाले उन्हीं लोगों को शामिल किया गया जो जानवरों के साथ काम करते थे।ऑस्ट्रेलियाई वेबसाइट का दावा है कि चीन और पाकिस्तान दिखावे के तौर पर पशुजन्य संक्रामक बीमारियों पर शोध कर रहे हैं लेकिन इसकी आड़ में जैविक हथियारों के लिए रिसर्च की जा रही है। फिलहाल इन वायरस से बचने की कोई वैक्सीन या सटीक इलाज नहीं है। इनमें से कुछ को दुनिया का सबसे घातक और संक्रामक वायरस माना जाता है। इन शोधों के लिए 'चीन-पाकिस्तान आर्थिक गलियारे के साथ जैव सुरक्षा की प्रमुख तकनीकों पर अंतरराष्ट्रीय सहयोग' के तहत सीपेक से आर्थिक मदद मिलने का जिक्र किया गया है।
ऑस्ट्रेलियाई वेबसाइट का कहना है कि चीन और पाकिस्तान के बीच एक समझौता किया गया है। इसके चलते दोनों देश संक्रामक बीमारियों पर शोध कर रहे हैं। हालांकि, इसकी आड़ में जैविक हथियारों के लिए रिसर्च की जा रही है। फिलहान इन वायरस से बचने की कोई वैक्सीन या सटीक इलाज नहीं है। इनमें से कुछ को दुनिया के सबसे घातक और संक्रामक वायरस माना जाता है।
